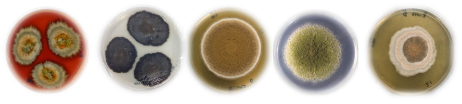

Dr Claudio Greco has worked at Swansea University since 2022. Claudio’s research focuses on the discovery and development of natural products, with a specific focus on fungi. Alongside his research, Claudio also supervises PhD students and teaches first and third year Biosciences students...
Tell me about your role...
I have been a lecturer in the Biosciences department at Swansea University for the past three years, and I’m currently teaching a natural products biotechnology module to third-year students. Outside of lecturing, my role is to lead my research group called Synthetic Microbiology and Natural Products. We are interested in discovering natural products from microbes, in particular from fungi.
Area of expertise?
My training is between chemistry, which I studied as an undergraduate, and biological chemistry/microbiology, which was my PhD focus. My expertise is mostly fungal natural products, biosynthesis, structural elucidation using chemical tools and fungal genetics. My lab has strong expertise in developing genetic tools to modify the fungal genome to examine and discover natural products.
I decided to follow my interest in fungi after training in organic synthesis. One of my supervisors informed me that there was a project that was at the interface between microbiology and chemistry, and they were looking into discovering natural products from fungal species for agrochemical applications. This opportunity led me to work with Syngenta and get more hands-on experience.
I always had an interest in the synthesis and biosynthesis of natural products but my interest in fungi came later. I worked on total synthesis, and with bacteria, but now I mostly focus on fungal secondary metabolites.
How are fungi used?
Fungi are amazing organisms that we can find in all aspects of life, including in our bodies. They play an incredibly important role in balancing environments, and they produce a variety of metabolites with a huge application for drug discovery. Fungi can also be used as a biomass to make sustainable biomaterials. From my viewpoint, fungi are an excellent producer of bioactive molecules with important ecological roles and potential for application in medicine and agriculture.
You can find fungi in food products, especially as a source of protein in vegetarian and vegan substitutes. Fungi are rich in protein as well as being a sustainable food source. You can grow them in a bioreactor, meaning they are not affected by environmental conditions, including weather or the application of pesticides. They are used to produce medicines such as penicillin, and their beneficial properties have been used throughout human history.
What is a natural product to you?
It’s really anything that’s connected to a natural source. For some, this might be using a whole microorganism, but from my side it’s about focusing on small molecules known as secondary metabolites.
How are you currently working with the NP BioHUB?
I’ve been involved with a couple of projects, and we’ve submitted some grants together. I also have co-supervision of some students and postdocs with other members of the NP BioHUB team. My areas of expertise are in analytical chemistry, such as mass spectrometry, chemical purification, as well as microbiology, fungal genetics and bioinformatics. This range of expertise between chemistry and microbiology allows me to support many of the BioHUB’s projects.
How can you help companies working with the GEC?
It’s not sector-specific, but my knowledge could be useful to agrichemical, medical, and food industries. I am happy to provide support in the discovery of fungal natural products, strain engineering, chemical analysis and biosynthesis. In addition, my group has access to a range of specialised equipment such as UHPLC-HRMS, preparative HPLC, a chemical extraction facility and microbiological equipment to work with CAT-I and CAT-II organisms. I am always interested in working with companies and developing projects together.
Current projects...
I’m currently working on two main projects. The first is a collaboration with Thailand, where we are screening an incredibly large Thai fungal collection for the discovery of new strains that can be used as biocontrols and can produce bioactive natural products to fight a range of plant diseases. The project is ongoing, but we have already discovered some exciting fungal strains with great potential in protecting different crops. The second project is looking into the role of natural products in the leaf-cutter ants microbiome. I am particularly interested in understanding the biosynthetic potential of the fungal pathogen and how its small molecules are used against the other organisms.
Future projects
My current project with Thailand could benefit from having someone dedicated to developing some genetic tools to help drive the project forward and maybe initiate some industrial collaboration. I am also interested in developing a Welsh fungal collection and discovering new fungal natural products.
If you’re interested in working with me, please get in touch at claudio.greco@swansea.ac.uk and take a look at my website >> www.grecolab.com